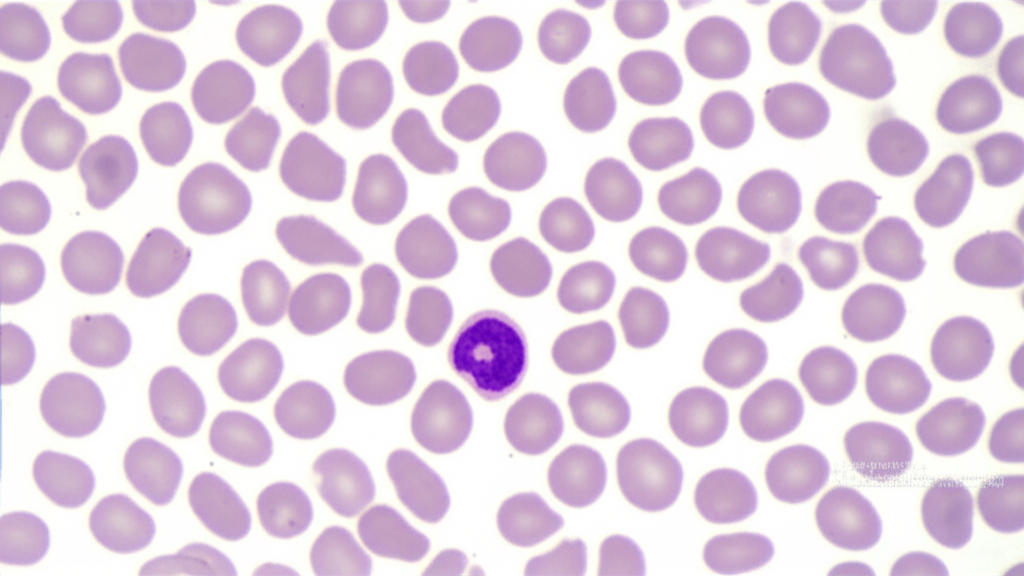

HCT (헤마토크릿)은 혈액 검사에서 가장 기본적인 동시에 매우 중요한 지표 중 하나입니다. 많은 분들이 건강검진 결과표에서 HCT 수치를 마주하고, 과연 나의 HCT 정상수치는 얼마인지, 이 수치가 무엇을 의미하는지 궁금해하시곤 합니다. 단순히 숫자를 넘어, HCT 수치는 우리 몸의 전반적인 건강 상태, 특히 혈액의 산소 운반 능력과 깊이 연관되어 있습니다. 이 글에서는 HCT가 무엇인지, 왜 우리 몸에서 그토록 중요한 역할을 하는지, 그리고 성별과 연령에 따른 HCT 정상수치 범위는 어떻게 되는지 상세히 살펴보겠습니다. 또한, HCT 정상수치를 벗어났을 때 발생할 수 있는 잠재적인 건강 문제들과 이를 예방하고 관리하기 위한 실질적인 생활 습관까지 종합적으로 다룰 예정입니다. 자신의 HCT 수치를 정확히 이해하고 관리하는 것은 건강한 삶을 위한 필수적인 첫걸음이 될 것입니다.
HCT란 무엇이며 왜 중요한가요?

HCT는 Hematocrit의 약자로, 우리 몸을 순환하는 혈액 전체 용량에서 적혈구가 차지하는 부피의 백분율을 의미합니다. 혈액은 액체 성분인 혈장과 고형 성분인 적혈구, 백혈구, 혈소판으로 구성되어 있는데, 이 중 적혈구는 폐에서 흡수한 산소를 온몸의 조직과 세포로 운반하고, 다시 이산화탄소를 폐로 되돌려 보내는 핵심적인 역할을 담당합니다. 따라서 HCT 수치는 우리 몸의 산소 운반 능력과 직접적인 상관관계를 가집니다. HCT 정상수치는 이러한 산소 운반 기능이 원활하게 이루어지고 있다는 것을 보여주는 중요한 생체 지표입니다. 만약 HCT 수치가 정상 범위를 벗어난다면, 이는 혈액의 산소 운반 능력에 문제가 생겼음을 시사하며, 빈혈이나 적혈구 증가증과 같은 다양한 혈액 관련 질환을 진단하고 그 경과를 모니터링하는 데 매우 유용하게 활용됩니다. 따라서 정기적인 HCT 수치 확인은 잠재적인 건강 문제를 조기에 발견하고 적절한 대응을 하는 데 결정적인 역할을 합니다.
HCT 정상수치는 얼마인가요?
HCT 정상수치는 성별, 나이, 그리고 검사를 진행한 의료기관의 기준에 따라 미세한 차이가 있을 수 있지만, 일반적으로 다음과 같은 범위로 알려져 있습니다. * 성인 남성: 보통 40~54% 사이를 HCT 정상수치로 간주합니다. 남성은 여성보다 적혈구 생성 호르몬의 영향으로 HCT 수치가 약간 더 높은 경향이 있습니다. * 성인 여성: 대개 36~48% 사이를 HCT 정상수치로 봅니다. 월경으로 인한 주기적인 철분 손실 때문에 남성보다 HCT 수치가 낮은 경우가 많습니다. * 어린이: 나이에 따라 HCT 정상수치가 달라지며, 성장 과정에 따라 변동 폭이 있습니다. 일반적으로 성인보다 약간 높은 경향을 보입니다. * 신생아: 출생 직후에는 약 45~65% 정도로 매우 높은 HCT 수치를 보이다가 점차 감소하여 유아기에는 성인과 유사한 수준으로 안정화됩니다. 이러한 HCT 정상수치는 단순한 참고치이며, 개개인의 건강 상태, 생활 습관, 유전적 요인 등에 따라 다르게 해석될 수 있습니다. 예를 들어, 고산 지대에 거주하는 사람들은 낮은 산소 농도에 적응하기 위해 HCT 수치가 자연스럽게 높아질 수 있습니다. 따라서 자신의 HCT 정상수치가 범위 내에 있더라도, 다른 혈액 검사 결과와 함께 종합적으로 판단하고, 이상이 의심될 경우 반드시 의료 전문가와 상담하여 정확한 진단과 해석을 받는 것이 중요합니다.
HCT 수치가 낮을 때 (빈혈)


HCT 수치가 HCT 정상수치보다 낮은 경우, 이는 빈혈을 의미할 수 있습니다. 빈혈은 혈액 내 적혈구의 수가 부족하거나 적혈구 내 헤모글로빈이 부족하여 체내 산소 공급이 원활하지 못한 상태를 말하며, 우리 몸의 모든 기관에 영향을 미칠 수 있습니다.
주요 원인
철분 결핍 빈혈: 가장 흔한 빈혈 형태로, 철분은 헤모글로빈 생성에 필수적인 요소입니다. 식단 부족, 흡수 장애, 출혈(위장관 출혈, 과도한 월경 등)이 주요 원인입니다.
만성 질환 빈혈: 신장 질환, 암, 류마티스성 관절염 등 만성 염증성 질환은 적혈구 생성을 억제하거나 적혈구 수명을 단축시킬 수 있습니다.
비타민 결핍 빈혈: 비타민 B12나 엽산은 적혈구 성숙에 필수적인 영양소입니다. 이들의 결핍은 거대적아구 빈혈을 유발할 수 있습니다.
골수 질환: 재생불량성 빈혈, 골수이형성 증후군과 같이 골수에서 적혈구 생성이 제대로 이루어지지 않는 경우입니다.
일반적인 증상
만성적인 피로감과 무기력함: 가장 흔한 증상으로, 충분한 휴식에도 불구하고 피로가 지속됩니다.
어지럼증, 두통, 집중력 저하: 뇌로 가는 산소 공급 부족으로 발생합니다.
창백한 피부와 점막: 혈액 내 적혈구가 적어 피부와 입술, 눈꺼풀 안쪽이 창백해 보입니다.
호흡 곤란, 가슴 두근거림: 심장이 부족한 산소를 보충하기 위해 더 빠르게 뛰면서 나타나는 증상입니다. HCT 정상수치 이하로 떨어진 HCT 수치는 위와 같은 증상과 함께 나타날 수 있으며, 장기간 방치할 경우 심장 기능 저하 등 더 심각한 건강 문제로 이어질 수 있습니다. 따라서 정상 수치 회복을 위해서는 반드시 원인을 파악하고, 철분제 복용, 식단 개선, 기저 질환 치료 등 적절한 의학적 조치를 취해야 합니다.
HCT 수치가 높을 때 (적혈구 증가증)
반대로 HCT 수치가 HCT 정상수치보다 높은 경우도 있습니다. 이는 적혈구 증가증이라고 불리며, 혈액이 너무 끈적해져 혈액 순환에 지장을 주거나 혈전 형성 위험을 높일 수 있습니다.
주요 원인
탈수: 체내 수분 부족으로 혈액 내 혈장량이 줄어들면서 상대적으로 적혈구 비율이 높아져 HCT 수치가 일시적으로 상승할 수 있습니다. 이는 HCT 정상수치 이상으로 나타날 수 있는 가장 흔한 비병리적 원인 중 하나입니다.
만성 폐 질환: 만성 폐쇄성 폐질환(COPD), 폐기종 등 폐 기능이 저하되면 혈액 내 산소 농도가 낮아지고, 이를 보상하기 위해 신장에서 적혈구 생성을 촉진하는 호르몬(에리스로포이에틴) 분비가 증가하여 적혈구 수가 늘어날 수 있습니다.
심장 질환: 선천성 심장병 등 심장 기능 부전으로 산소 공급이 원활하지 않을 때도 보상 작용으로 적혈구가 증가할 수 있습니다.
흡연: 흡연은 혈액의 산소 운반 능력을 저하시키고, 일산화탄소 중독과 유사한 효과를 일으켜 적혈구 생성을 늘릴 수 있습니다.
진성 적혈구 증가증 (Polycythemia Vera): 골수에서 적혈구, 백혈구, 혈소판 등 혈액 세포가 과도하게 생성되는 희귀 혈액암입니다.
일반적인 증상: 두통, 어지럼증, 시야 흐림: 혈액의 점도가 높아져 뇌로 가는 혈류가 느려지면서 발생합니다. *
피로감, 무기력함: 높은 HCT 수치 자체로 인해 나타날 수 있습니다.
피부 붉어짐 (특히 얼굴과 손발): 혈액량이 많아지면서 피부색이 붉게 보일 수 있습니다.
손발 저림, 가려움증, 이명: 혈액 순환 장애와 관련이 있습니다. 따라서 정상 범위를 초과하는 높은 HCT 수치는 뇌졸중, 심근경색 등 심혈관 질환의 위험을 증가시킬 수 있으므로, 반드시 원인을 정확히 파악하고 적절한 치료와 관리를 통해 정상 수치로 되돌리려는 노력이 필요합니다.
HCT 정상수치 유지를 위한 생활 습관
HCT 정상수치를 유지하고 전반적인 혈액 건강을 증진시키기 위해서는 일상생활에서의 꾸준한 노력이 매우 중요합니다. 다음은 건강한 HCT 수치를 위한 실질적인 생활 습관 가이드입니다. 1. 균형 잡힌 식단 유지: * 철분 섭취: HCT 수치가 낮은 경우, 철분이 풍부한 식품(붉은 살코기, 닭고기, 생선, 콩류, 시금치, 브로콜리 등)을 충분히 섭취하는 것이 중요합니다. * 비타민 C 섭취: 비타민 C는 식물성 철분의 흡수를 돕는 강력한 조력자입니다. 오렌지, 딸기, 키위, 파프리카 등 비타민 C가 풍부한 과일과 채소를 철분 함유 식품과 함께 섭취하세요. * 엽산 및 비타민 B12: 적혈구 생성에 필수적인 엽산(녹색 잎채소, 견과류, 곡물)과 비타민 B12(육류, 생선, 유제품)를 충분히 섭취하는 것이 좋습니다. 2. 충분한 수분 섭취: HCT 수치가 높은 경우, 탈수가 주원인일 수 있습니다. 하루 8잔 이상의 물을 규칙적으로 마셔 체내 수분 균형을 유지하는 것이 중요합니다. 특히 운동 후나 더운 날씨에는 수분 섭취에 더욱 신경 써야 합니다. 이는 HCT 정상수치 유지에 기본이 되는 습관입니다. 3. 금연 및 절주: 흡연은 혈액의 산소 운반 능력을 저하시켜 HCT 수치 상승을 유발할 수 있으며, 과도한 음주는 골수 기능을 저해하고 영양소 흡수를 방해하여 HCT 수치에 부정적인 영향을 미칠 수 있습니다. HCT 정상수치를 위한 건강한 선택은 금연과 절주입니다. 4. 정기적인 건강검진: 자신의 HCT 정상수치를 파악하고, 수치 변화를 조기에 발견하기 위해 최소 1년에 한 번은 정기적인 건강검진을 받는 것이 매우 중요합니다. 특히 만성 질환이 있거나 가족력이 있는 경우, 혹은 특정 증상이 나타날 때는 의사와 상담하여 필요한 검사를 받아야 합니다. 5. 적절한 운동: 규칙적인 유산소 운동은 혈액 순환을 개선하고 전반적인 신체 기능을 향상시켜 혈액 건강 유지에 도움을 줍니다. 다만, 너무 과도한 운동은 일시적으로 HCT 수치에 영향을 줄 수 있으므로, 자신의 몸 상태에 맞는 적절한 강도로 운동하는 것이 중요합니다.
FAQ: HCT 정상수치에 대해 궁금한 점



Q1: HCT 검사는 어떻게 진행되나요?
A1: HCT 검사는 일반적으로 '전혈구 검사(CBC, Complete Blood Count)'의 한 항목으로 진행됩니다. 팔의 정맥에서 소량의 혈액(보통 5~10ml)을 채취하여 검사실로 보냅니다. 특별히 금식이 요구되는 검사는 아니지만, 다른 혈액 검사와 함께 진행될 경우 금식이 필요할 수 있으므로, 검사 전 안내 사항을 잘 확인하는 것이 좋습니다. 검사 시간은 매우 짧으며, 결과는 보통 몇 시간에서 하루 이내에 확인 가능합니다. HCT 정상수치 확인을 위한 가장 기본적인 검사입니다.
Q2: HCT 수치는 왜 변동될 수 있나요?
A2: HCT 수치는 매우 역동적이며, 다양한 내외부 요인에 의해 일시적으로 또는 장기적으로 변동될 수 있습니다. 예를 들어, 심한 탈수 상태에서는 혈액이 농축되어 HCT 수치가 일시적으로 높아질 수 있고, 급성 출혈이 발생하면 HCT 수치가 급격히 낮아질 수 있습니다. 또한, 고산 지대에 거주하는 경우, 흡연 여부, 임신, 특정 약물 복용 등도 HCT 수치에 영향을 미칩니다. 따라서 HCT 정상수치를 벗어났다고 해서 항상 심각한 질병을 의미하는 것은 아니며, 의사는 환자의 전반적인 건강 상태, 생활 습관, 다른 검사 결과 등을 종합하여 판단하게 됩니다.
Q3: HCT 정상수치가 아닌 경우 반드시 질병인가요?



A3: 아닙니다. HCT 정상수치를 벗어났다고 해서 무조건 질병이 있다고 단정할 수는 없습니다. 위에서 설명했듯이 탈수, 고산 지대 거주, 심한 운동 등의 일시적인 요인으로 인해 수치가 변동될 수 있습니다. 하지만 지속적으로 HCT 정상수치를 벗어나거나, 관련 증상(피로, 어지럼증, 숨 가쁨 등)이 동반될 경우, 빈혈, 적혈구 증가증, 골수 질환, 신장 질환, 폐 질환 등 기저 질환의 가능성을 배제할 수 없습니다. 따라서 이상 수치가 발견되면 반드시 의료 전문가와 상담하여 정확한 원인을 파악하고 적절한 조치를 취하는 것이 중요합니다.
Q4: HCT 수치 관리가 중요한 이유는 무엇인가요?
A4: HCT 수치 관리는 우리 몸의 전반적인 건강과 직결되기 때문에 매우 중요합니다. HCT 정상수치 유지는 혈액이 우리 몸의 각 조직과 장기에 충분한 산소를 공급하여 모든 기능이 원활하게 작동하도록 돕습니다. 만약 HCT 수치가 너무 낮으면 빈혈로 인해 만성 피로, 무기력증, 심장 기능 저하 등의 문제가 발생할 수 있으며, 심한 경우 생명을 위협할 수도 있습니다. 반대로 HCT 수치가 너무 높으면 혈액의 점도가 높아져 혈액 순환 장애를 일으키고, 뇌졸중, 심근경색과 같은 심혈관 질환 및 혈전 형성 위험이 크게 증가합니다. 따라서 HCT 정상수치를 유지하는 것은 건강한 삶을 영위하는 데 필수적인 요소입니다.
결론: HCT 수치는 우리 몸의 혈액 건강과 산소 운반 능력을 가늠하는 매우 중요한 지표입니다. HCT 정상수치를 정확히 이해하고 자신의 수치를 정기적으로 확인하는 것은 잠재적인 건강 문제를 조기에 발견하고 예방하는 데 큰 도움이 됩니다. 건강한 식단, 충분한 수분 섭취, 금연 및 절주, 규칙적인 운동, 그리고 무엇보다 정기적인 건강검진을 통해 HCT 정상수치를 유지하려는 노력이 필요합니다. 만약 HCT 수치에 이상이 발견되거나 관련 증상이 있다면 주저하지 말고 의료 전문가와 상담하여 정확한 진단과 개별 맞춤 치료를 받는 것이 중요합니다. HCT 정상수치에 대한 꾸준한 관심과 관리가 바로 건강하고 활기찬 삶의 기반이 될 것입니다.